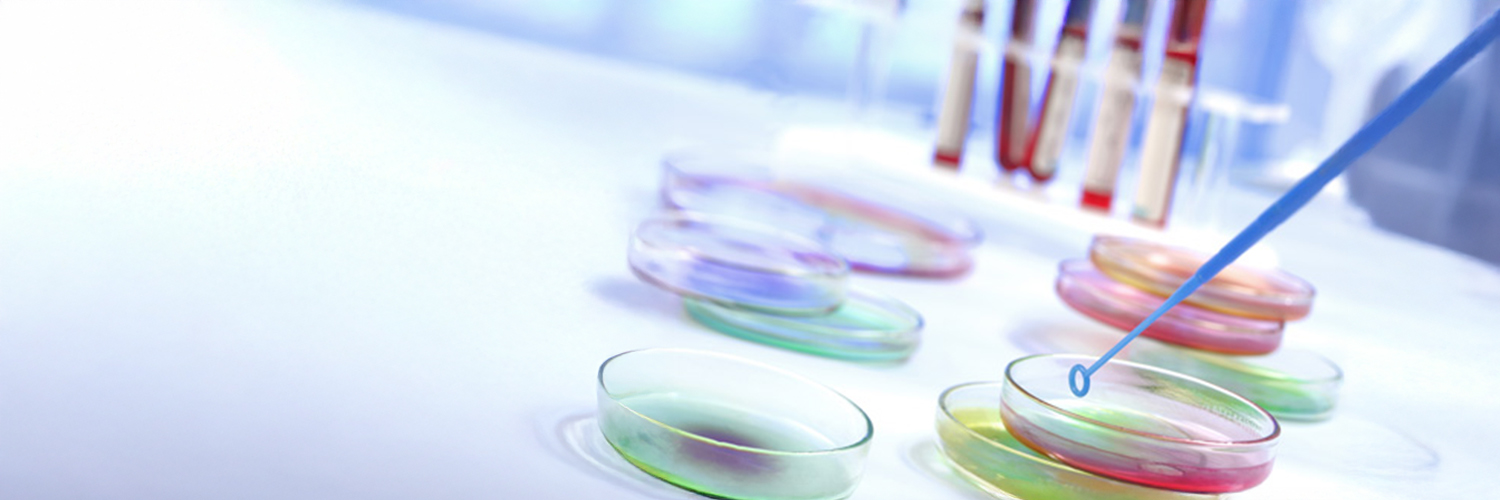
© Fotolia - Jpc prod boîte de Petri en verre pour analyse microbiologique

FR
L’ensemble de ce type de prélèvement est réalisé techniquement par le biais d’un prélèvement ponctuel, après avoir respecté de multiples règles ou précautions afin de ne pas contaminer l’échantillon recueilli.
Les prélèvements sont réalisés sous accréditation COFRAC.
On distingue deux grandes familles pour ce type de prélèvement :
Les prélèvements pour analyses sur les eaux de consommation, dans le but de vérifier la conformité de l’eau consommée, arrêté du 21/01/2010 (analyse de type D1) ou de vérifier l’absence de risque sur la santé, arrêté du 01/02/2010 (légionelle).
Ce type de prélèvement s’effectue sur des robinets de consommation ou des douches dans les réseaux d’eau froide ou chaude.
Les prélèvements sur les Tours aéroréfrigérantes (TAR, légionelles) s’effectuent davantage dans un cadre réglementaire (arrêté du 14/12/2013).
La périodicité de ce type de contrôle dépend du classement de votre installation ou de votre catégorie, mais également des résultats des mesures précédentes.
Généralement, un contrôle annuel est réalisé. Pour les TAR ce contrôle peut dans certains cas être mensuel.
L'objectif du prélèvement pour analyses des eaux de consommation est de rechercher la présence de micro-organismes (bactéries, virus et parasites) dans les eaux de consommation, afin de vérifier la qualité du traitement de la désinfection et de garantir une utilisation sans risque par le consommateur.
La présence de micro-organismes dans l’eau de consommation peut engendrer un risque à court terme pour le consommateur. Le tableau clinique des pathologies engendrées est le plus souvent bénin pour la population générale (troubles gastro-intestinaux, diarrhées…).
L'objectif du prélèvement et analyses légionelles est de rechercher la présence de légionelles dans les installations où la présence et la prolifération de ces bactéries est possible, eau froide sanitaire (EFS), eaux chaudes sanitaires (ECS), dans les installations de refroidissement par dispersion d’eau dans un flux d’air (IRDEFA) ou tour aéroréfrigérante (TAR), dans les eaux d’agrément et eaux naturelles.

Sont concernés par ce type de prélèvements :
Pour les établissements recevant du public, l’arrêté du 1er février 2010 relatif à la surveillance des légionelles dans les installations de production, de stockage et de distribution d'eau chaude sanitaire, fixe une fréquence annuelle de prélèvement.
Pour les industriels, les arrêtés du 14 décembre 2013 relatif aux prescriptions générales applicables aux installations relevant du régime de déclaration ou de l'enregistrement au titre de la rubrique n° 2921 de la nomenclature des installations classées pour la protection de l'environnement, la fréquence est respectivement bimensuelle (1/2 mois) et mensuelle pour les installations soumises au régime de l’enregistrement.
L’arrêté du 11 janvier 2007 relatif au programme de prélèvements et d'analyses du contrôle sanitaire pour les eaux fournies par un réseau de distribution, pris en application des articles R. 1321-10, R. 1321-15 et R. 1321-16 du code de la santé, fixe les fréquences de prélèvement.
La méthodologie de prélèvement diffère en fonction de la typologie d’analyse à réaliser (D1, D2, P1, P2, RP ou RS).